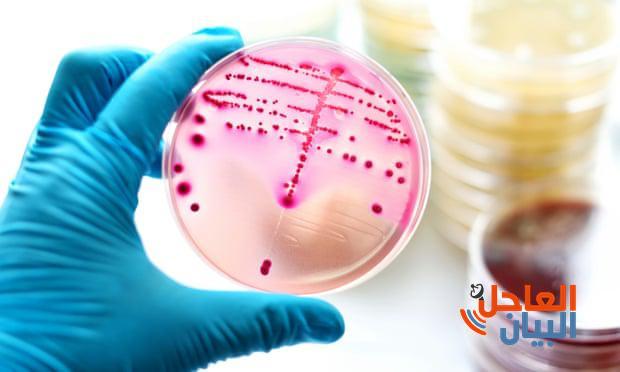
المضادات الحيوية

قضية رأي: قلة المضادات الحيوية في البلدان ذات الدخل المنخفض, بالرغم من إرتفاع معدلات الإصابة بالأمراض
لاتتوفر العديد من المضادات الحيوية في الكثير من البلدان الفقيرة, بالرغم من أرتفاع نسبة الأصابة بالأمراض, مما يضاعف أحتمالية وجود عقاقير مضادة للأدوية, وفقاً للتقرير الذي سيقدم لقادة الدول ورؤساء كبار شركات الأدوية في مؤتمر (دافوس) الدولي بسويسرا.
وأشارت بعض التقارير ألى أن عدد الأدوية التي يتم تطويرها لمكافحة الألتهابات والأمراض الأخرى الشائعة(مثل السل والسيلان والألتهابات) قد أنخفض.
هذا وقد أصبحت الألتهابات أكثر صعوبة في العلاج, وفي عام (2018) تم تشخيص أول حالة أصابة مقاومة لجميع أنواع المضادات الحيوية لرجل بريطاني أصيب بالسيلان.
وفي البلدان الفقيرة عندما لاتتوفر أفضل أنواع المضادات الحيوية, يجبر الأطباء في كثير من الأحيان ألى أستخدام الأدوية الرديئة أو تأخير العلاج.
وتعاني البلدان الفقيرة من أرتفاع معدلات مقاومة العقاقير, بينما تكافح الجهات المختصة لتوفير أدوية فعالة.
ووجد التقرير أنه من بين (13) من المضادات الحيوية المطورة حديثاً يوجد (3) فقط متاحة في(10)أو أكثر من (102) من الدول التي تعتبر متوسطة أو فقيرة.
ويقول التقرير أن عدد الأشخاص الذين يموتون بسبب عدم المقدرة على الحصول على الدواء في تضاعف بسبب مقاومة الدواء.